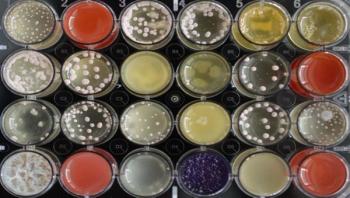

News



Though the West African Ebola outbreak that began in 2013 is now under control, 23 countries remain environmentally suitable for animal-to-human transmission of the Ebola virus. Only seven of these countries have experienced cases of Ebola, leaving the remaining 16 countries potentially unaware of regions of suitability, and therefore underprepared for future outbreaks.

The atomic structure of an elusive cold virus linked to severe asthma and respiratory infections in children has been solved by a team of researchers at the University of Wisconsin-Madison and Purdue University. The findings are published this week in the Proceedings of the National Academy of Sciences (PNAS) and provide the foundation for future antiviral drug and vaccine development against the virus, rhinovirus C.

Besides mushrooms such as truffles or morels, also many yeast and mold fungi, as well as other filamentous fungi belong to the Ascomycota phylum. They produce metabolic products which can act as natural antibiotics to combat bacteria and other pathogens. Penicillin, one of the oldest antibiotic agents, is probably the best known example. Since then, fungi have been regarded as a promising biological source of antibiotic compounds. Researchers expect that there is also remedy for resistant pathogens among these metabolites.

A new type of HIV drug currently being tested works in an unusual way, scientists in the Molecular Medicine Partnership Unit, a collaboration between EMBL and Heidelberg University Hospital, have found. They also discovered that when the virus became resistant to early versions of these drugs, it did not do so by blocking or preventing their effects, but rather by circumventing them. The study, published online today in Science, presents the most detailed view yet of part of the immature form of HIV.

















For the first time in the world, a group of researchers discovered a human immune receptor, which detects the invasion of pathogenic microorganisms. They thereby succeeded in identifying a so far unknown host defense mechanism. These results will contribute to future developments in the treatment and prevention of infectious diseases.





In an article published in PLoS Genetics on July 5, scientists from the Institut Pasteur and the Belgian-based Université catholique de Louvain identify for the first time the genetic and metabolic mechanisms underpinning the therapeutic action of a bacteriophage known for its therapeutic potential. Given the worrying rise in bacterial resistance to antibiotics and the difficulties in developing effective new molecules, there has been renewed interest within the scientific community in recent years in phage therapy, which makes use of these bacterial viruses. This discovery will contribute to ongoing efforts to develop this treatment, which has been largely neglected in Western countries.